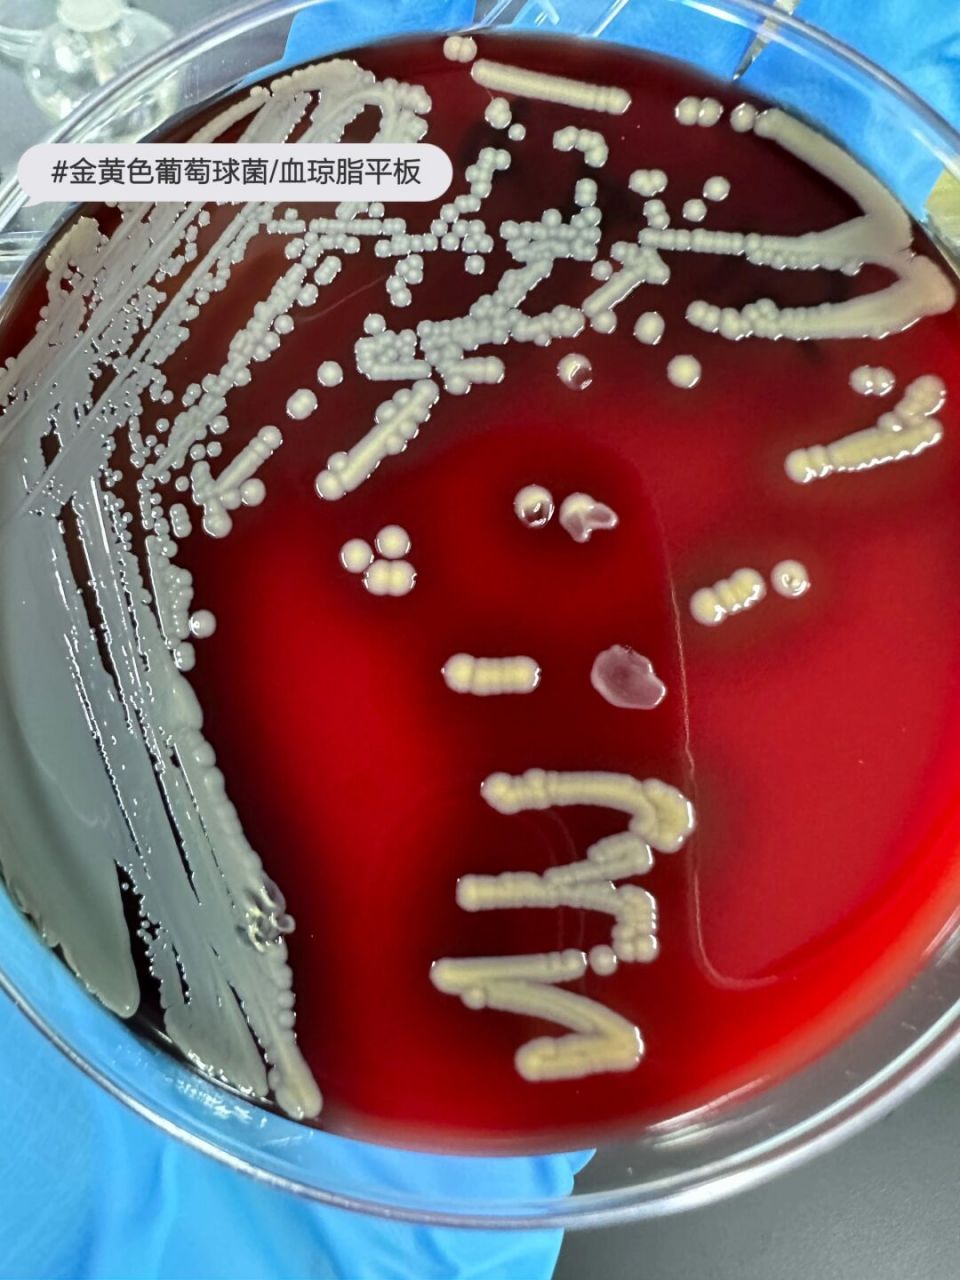
金黄色葡萄球菌 #医学检验# #微生物#
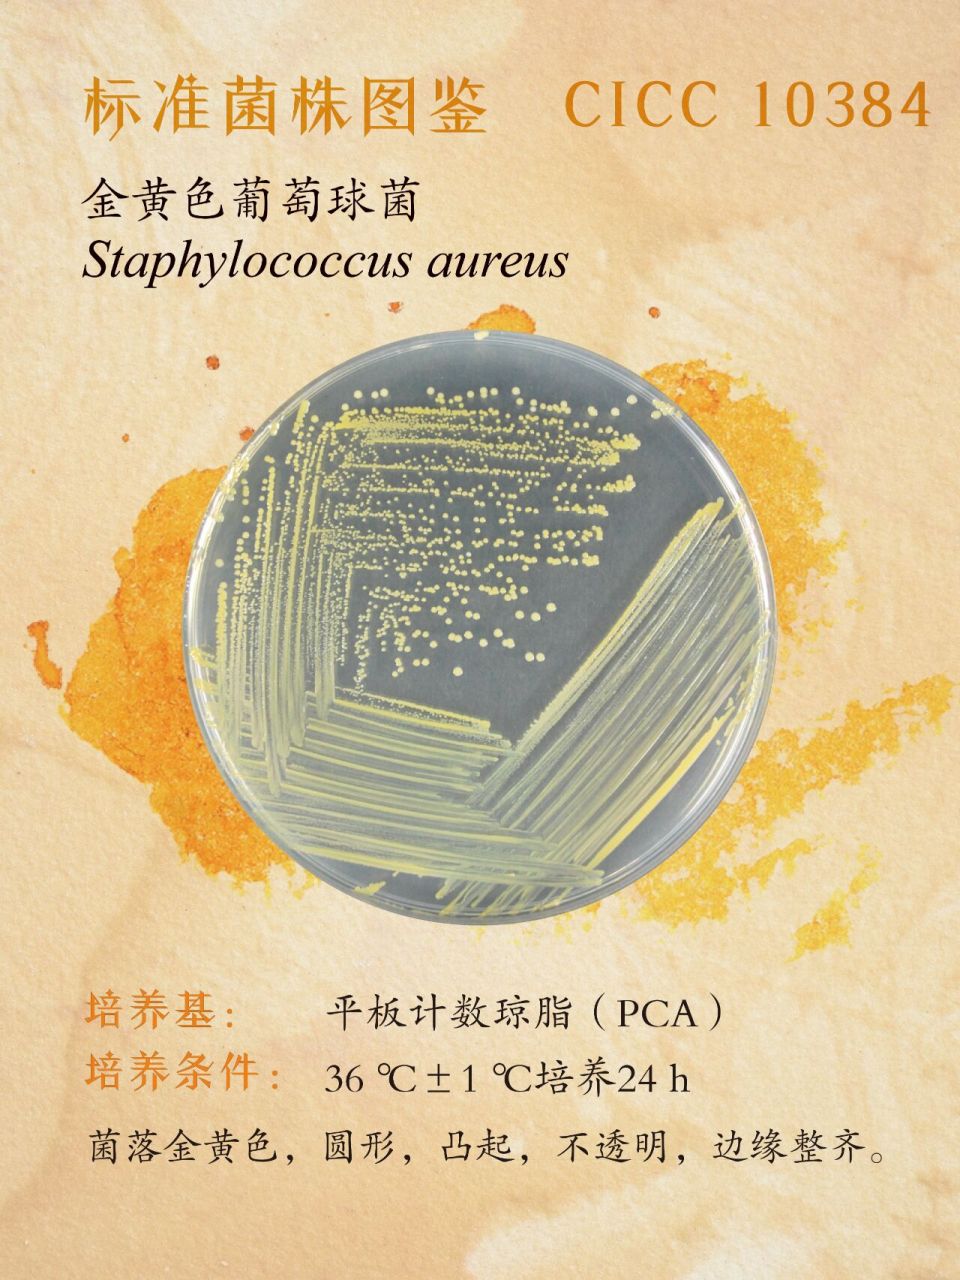
每日一菌丨金黄色葡萄球菌 cicc10384 细菌界(bacteria)• 厚壁菌门

金葡萄球菌

金黄色葡萄球菌 1⃣️形态:革兰阳性球菌,直径0.5~1.5μm,呈单/
图片尺寸1706x1280
国健检测小课堂丨揭示你不了解金色葡萄球菌
图片尺寸472x472
金黄色葡萄球菌 #医学检验# #微生物#
图片尺寸960x1280
每日一菌丨金黄色葡萄球菌 cicc10384 细菌界(bacteria)• 厚壁菌门
图片尺寸960x1280
#今日分享 各种各样的金黄色葡萄球菌,有的溶血环大,有的溶血 - 抖音
图片尺寸1440x2116
金黄色葡萄球菌 - 知乎
图片尺寸480x500
金黄色葡萄球菌 1⃣️形态:革兰阳性球菌,直径0.5~1.5μm,呈单/
图片尺寸960x1280
金葡菌肺炎的完整转归——鹤壁人医 汪涛 - 美篇
图片尺寸600x800
革兰染色第二次—金黄色葡萄球菌,漂亮的紫色差点被我拍成黑色
图片尺寸1440x1080
人体皮肤的金黄色葡萄球菌抗菌乳膏 林旦软膏30g【1支】
图片尺寸800x800
金黄色葡萄球菌 1⃣️形态:革兰阳性球菌,直径0.5~1.5μm,呈单/
图片尺寸960x1280
显微镜下的金黄葡萄球菌喔
图片尺寸1080x1439
耐甲氧西林金黄色葡萄球菌(mrsa),各种抗…-堆糖,美好生活研究所
图片尺寸700x486
金黄色葡萄球菌性脑膜炎死亡率为17%,治疗根据年龄进行抗生素治疗-常
图片尺寸659x471
广泛存在的金黄色葡萄球菌
图片尺寸640x360
金黄色葡萄球菌
图片尺寸1080x1080
6.致病菌主要为金黄色葡萄球菌感染急性脓胸,疖,痈,手部感染,急性肝脓
图片尺寸1280x720
金葡萄素材-金葡萄图片-金葡萄素材图片下载-觅知网
图片尺寸1280x853
金黄色葡萄球菌
图片尺寸960x1280
金黄色葡萄球菌 - 微生物 - 培养/筛选 - 小木虫论坛-学术科研互动平
图片尺寸675x900